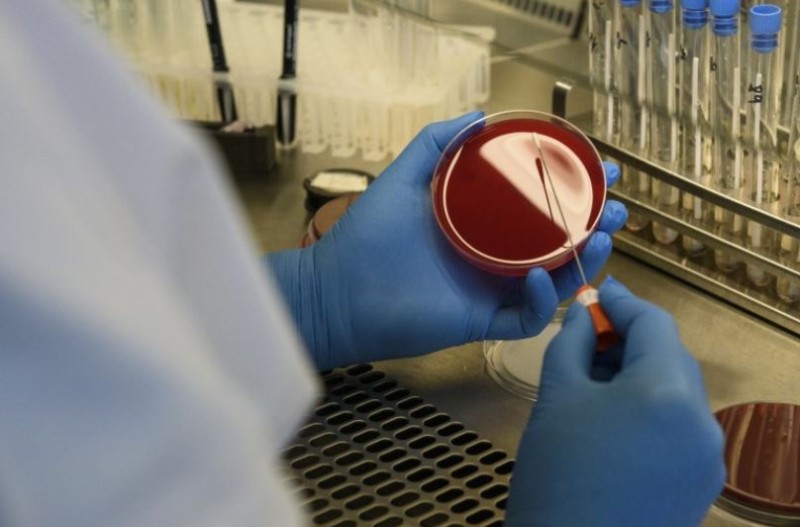

Medicul parazitolog Gheorghe O. Lupaşcu, membru corespondent al Academiei Române, s-a născut la 22 martie 1908, la Botoşani. S-a stins din viață la vârsta de 71 de ani, pe 19 noiembrie 1979, la Bucureşti.
Şi-a făcut studiile liceale la Botoşani, urmate de cele universitare, la Facultatea de Ştiinţe din Bucureşti, luându-şi licenţa în 1932. În 1946 şi-a susţinut teza de doctorat - "Studii asupra culicidelor din România". Şi-a continuat specializarea asupra biochimiei ţânţarilor anofeli, la Institutul Superior de Medicină din Roma (1940).

Cunoştinţele sale în domeniul parazitologiei au fost recunoscute şi în străinătate, fiind consultant al Organizaţiei Mondiale a Sănătăţii, calitate în care a întreprins călătorii de studii, privind lupta împotriva malariei, în ţări din Africa.
Rezultatul cercetărilor sale s-a concretizat în lucrări importante: "Malaria" (1943), "Principii şi metode ale eradicării malariei" (1957), "Hidatidoza" (1968), "Trichineloza" (1970), "Paraziţi cu patogenitate condiţionată" (1972), "Hidatidoza, o zoonoză cu grave repercusiuni în patologia umană" (1972).
Membru al Societăţii de Parazitologie Exotică din Paris şi al Societăţii Regale de Medicină şi Igienă din Londra. Membru corespondent al Academiei Române din 1 noiembrie 1948.
A murit la 19 noiembrie 1979, la Bucureşti.
A fost colaboratorul profesorului Mihai Ciucă în probleme de entomologie medicală precum vectorii bolilor transmisibile. Domeniul său principal de activitate a fost combaterea malariei în România și Africa, precum și controlul hidatidozei, echinococozei și al cisticercozei.
A derulat campanii de eradicarea speciilor de anofeli în România, în special în Dobrogea, împreună cu Maria Duport. Mare amator de artă și pictură pe sticlă.